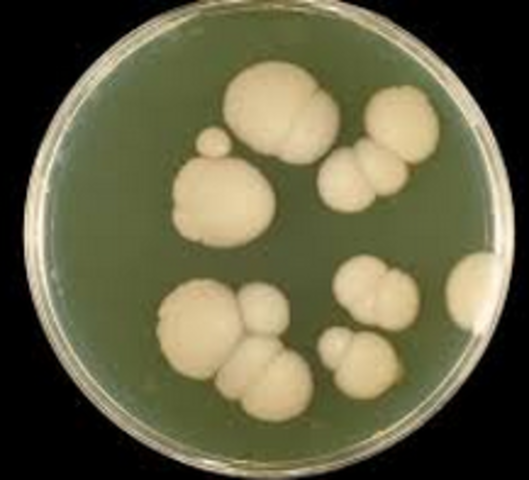
levadura es un microorganismo

-
Aristóteles es el verdadero creador de la biología científica. Estudió y describió más de 500 especies de animales y estableció la primera clasificación de los organismos.
-
-
Jerome Boch elaboró la primera clasificación de las plantas basado en sus relaciones, queaspiraba ser un sistema natural de agrupamiento
-
Andres Vesalio publicó el libro “De la estructura del cuerpo humano” y seconsideró el primer libro correcto de la anatomía humana y practicó la disección humana
-
Tycho Brahe observa una supernova,describiendo sus observaciones y mostrando que los cielos no son inmutables.
-
Guillermo de Baillou descubrió clínicamente la tos ferina es una infección de las vías respiratoria altas, causada por las bacterias
-
El microscopio fue inventado por un fabricante de anteojos de origen holandés, llamado Zaccharias Janssen
-
Robert Hooke fue el primero que, al ver en esos tejidos unidades que se repetían a modo de celdillas de un panal, las bautizó como elementos de repetición, «células»
-
Antón Van Leeuwenhoek por medio de un Microscopio descubre accidentalmente los microorganismos en una gota de agua.
Antón Van Leeuwenhoek por medio de un Microscopio descubre accidentalmente los microorganismos en una gota de agua -
Antonio Van Leeuwnenhoek descubre los protozoarios viven en ambientes húmedos o directamente en medios acuáticos, ya sean aguas saladas o aguas dulces. La reproducción puede ser asexual por bipartición y también sexual por isogametos o por conjugación intercambiando material genético
-
-
Juan Ham descubre los espermatozoides
-
Van Leeuwnenhoek descubre que la levadura es un microorganismo
-
Cuvier contaba con los huesos de mastodontes y otras criaturas aún más raras y llegó a ser habilísimo en interpretarlos y cautivó a la ciencia con su capacidad de reconstruir un animal partiendo de un puñado de huesos
-
Jan Ingenhousz descubre que las plantas reaccionan a la luz solar de manera diferente a la sombra. Nacen Las bases de la comprensión de la fotosíntesis.
La fotosíntesis es un proceso en el cual las plantas, algas y algunas bacterias convierten la energía de la luz en energía química. -
Estudiando una orquídea, el botánico Robert Brown identifica una estructura dentro de las células que él llama el "núcleo".
-
Schwann sugiere que el óvulo es un sola célula
-
Hugo Von Mohl propuso que se llamara protoplasma al contenido celular
-
En 1859 se inicia el Evolucionismo cuando Darwin publica el libro “El Origen de las especies por medio de la selección natural, o la preservación de las razas preferidas en la lucha por la vida”.
-
conjunto de reglas básicas sobre la transmisión por herencia de las características de los organismos padres a sus hijos
-
El ADN lo aisló por primera vez, durante el invierno de 1869, el médico suizo Friedrich Miescher, Lo llamó nucleína, debido a que lo había extraído a partir de núcleos celulares.
-
Walther Flemming observa que las células animales se dividen en etapas y llama a al proceso Mitosis.
-
como muchas otras ciencias, alcanzó la primera expresión definida de sus principios y problemas en la Grecia clásica y, posteriormente, continuó su desarrollo durante la época del Imperio romano
-
W. S. Sutton señaló que los cromosomas controlan la herencia de los caracteres físicos.
-
es una teoría expuesta por Louis Pasteur según la cual toda enfermedad infecciosa tiene su causa (etiología) en un germen con capacidad para propagarse entre las personas. Esta sencilla idea representa el inicio de la medicina científica, al demostrar que la enfermedad es el efecto visible (signos y síntomas) de una causa que puede ser buscada y eliminada mediante un tratamiento específico
-
Alexander descubre el efecto tóxico que causa en ciertas bacterias un producto de mohos
-
Hans Krebs identifica los pasos que la célula necesita para convertir los azúcares, grasas y proteínas en energía. También conocido como el ciclo del ácido cítrico, es una serie de reacciones químicas utilizando oxígeno como parte de la respiración celular. El ciclo contribuye a la descomposición de los carbohidratos, grasas y proteínas en dióxido de carbono y agua
-
23 pares de cromosomas en las células del cuerpo humano.
-
Roberth H Whittaker propuso una clasificacion de los seres vivos en 5 reinos: Animal, vegetal, monera, protisto y hongo.
-
La planta transgénica contiene uno o más genes que han sido insertados en forma artificial en lugar de que la planta los adquiera mediante la polinización
-
Investigadores, liderados por Ian Wilmut clonan al primer mamífero